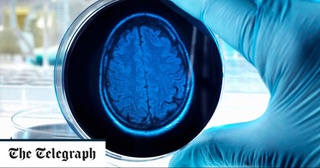
Aлцгеймер касаллигининг давоси 2040 йилгача топилиши мумкин

18
АПР
13:56

Чимкентда 10 ёшли боланинг миясидан 10 дан ортиқ қурт олиб ташланди
Қозоғистоннинг Чимкент шаҳрида шифокорлар 10 ёшли боланинг миясидан улкан эхинококк кистасини олиб ташлашди. Бундан олдин бола доимий бош оғриғидан азият чекарди.